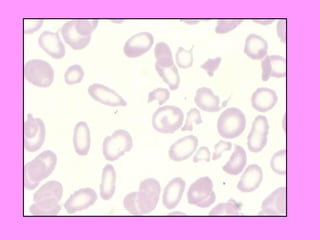

Recommended
PDF
PDF
CPG มะเร็งเม็ดเลือดขาวและต่อมน้ำเหลืองในผู้ใหญ่
PPTX
PPT
PDF
แนวทางเวชปฏิบัติในการรักษาผู้ป่วยมาลาเรียในประเทศไทย พ.ศ.2557
PDF
ACTEP2014: ED accreditation HA JCI TQA
PPTX
Drug Therapy of Hypertension
PDF
PDF
การดูแลเครื่องมือและอุปกรณ์ในการบำบัด
PDF
เอกสารประกอบการสอนวิชาเภสัชบำบัด ๓ (๗๙๑๕๕๑) หัวข้อ Assessment of Adverse drug...
PDF
12 กิจกรรมทบทวนภาคปฏิบัติ - Suradet Sriangkoon
PDF
PPT
PDF
PPT
Thalassemia screening in pregnancy, Quality improvement and Evidence based pr...
PPT
PDF
การพยาบาลผู้ป่วยที่มีปัญหา ของระบบทางเดินหายใจ
PDF
2016 Respiratory Assessment
PDF
PDF
Clinical practice guidelines for epilepsy
PDF
การดูแลผู้บาดเจ็บที่ทรวงอก
PDF
DOC
PDF
PDF
1.6.3 สารอาหารทางหลอดเลือดดำ
PDF
PPTX
Clinical practice guidelines mild head injury
PDF
PDF
PPS
More Related Content
PDF
PDF
CPG มะเร็งเม็ดเลือดขาวและต่อมน้ำเหลืองในผู้ใหญ่
PPTX
PPT
PDF
แนวทางเวชปฏิบัติในการรักษาผู้ป่วยมาลาเรียในประเทศไทย พ.ศ.2557
PDF
ACTEP2014: ED accreditation HA JCI TQA
PPTX
Drug Therapy of Hypertension
PDF
What's hot
PDF
การดูแลเครื่องมือและอุปกรณ์ในการบำบัด
PDF
เอกสารประกอบการสอนวิชาเภสัชบำบัด ๓ (๗๙๑๕๕๑) หัวข้อ Assessment of Adverse drug...
PDF
12 กิจกรรมทบทวนภาคปฏิบัติ - Suradet Sriangkoon
PDF
PPT
PDF
PPT
Thalassemia screening in pregnancy, Quality improvement and Evidence based pr...
PPT
PDF
การพยาบาลผู้ป่วยที่มีปัญหา ของระบบทางเดินหายใจ
PDF
2016 Respiratory Assessment
PDF
PDF
Clinical practice guidelines for epilepsy
PDF
การดูแลผู้บาดเจ็บที่ทรวงอก
PDF
DOC
PDF
PDF
1.6.3 สารอาหารทางหลอดเลือดดำ
PDF
PPTX
Clinical practice guidelines mild head injury
PDF
Viewers also liked
PDF
PPS
PPTX
G6PD Deficiency in Malaysia: the current situation - Narazah Mohd Yusoff
PPTX
PPT
PPTX
The ant and the corporation - 2nd Edition
PPT
DOCX
DOC
PPT
PPTX
Future World Giving - Recognising the potential of middle class giving
PPTX
PPSX
PPT
The Thrill Of Negotiating
PPTX
How to succeed as club president
PPT
PPTX
Md2010 jl-wp7-sl-game-dev
PPT
PPTX
PPTX
How to succeed as VP Public Relations
Similar to Appoarch anemia
PPT
PDF
Clinical practice guideline_of_anemia(cpg)
PPT
Cp 50 10-18 4 talk lab - class slide ha
PPT
PDF
PDF
Compre step 2_2010 si key
PDF
PDF
โปรแกรมตรวจสุขภาพ 13 รายการ 999 บาท
PPT
Transfusion and complications 2011
PPT
PPT
Cp 50 10-18 1 congenital & acquired ha
PDF
Cpg thalassemia 2014-content 2
PDF
PDF
Cpg thalassemia 2014-content
PDF
PPT
งานให้ความรู้เรื่องThalของหมอนภมาศ
PPTX
2010_PMC Cardiovascular-Blood Disorder
PPT
PDF
PDF
Appoarch anemia 1. 2. 3. Criteria for Diagnosis Anemia Hb.( g/dl) Hct (%) Children 11.0 33 Male 13.0 40 Female ( 15-50 ) 12.0 36 Female ( > 50 ) 13.0 40 Pregnant women 11.0 33 4. Mechanism of anemia 1. Decreased RBC production - Nutritional deficiency - Aplastic anemia - Myelophthisis anemia - Chronic renal failure 5. 2. Increased RBC destruction Intravascular hemolysis Extravascular hemolysis Mechanism of anemia 6. 7. - dizziness - confusion - coma - fatigue - dyspnea - edema - chest pain Anemic symptoms CNS CVS - onset 8. 9. 10. 11. Acute anemia Acute blood loss Acute hemolysis History of GI bleeding hypermenorrhea History of dark urine jaundice 12. Acute anemia Acute blood loss Acute hemolysis - G-6-PD def - Mis-match - Hb H with crisis - HS with crisis - AIHA Intravascular Extravascular 13. Chronic anemia Dietary intake Absorption Chronic blood loss Bleeding tendency Family history Hx of blood transfusion Hx of dark urine AA Myeloph. Iron def. CRF Megaloblastic PNH MAHA Thalassemia HS BM failure Precursors RBC production Hemolysis IVH EVH 14. 15. 16. 17. 18. 19. 20. 21. 22. 23. 24. 25. 26. 27. 28. 29. 30. CBC and RBC indices 80-96 fl. 27-33 pg. 33-36 g/dl 12.0-13.6% 31. MCV Iron deficiency thalassemia lead poisoning B6 deficiency reticulocytosis megaloblastic anemia AA liver disease MCV MCV 32. 33. Blood smear การติดสี ขนาดเซลล์ anisocytosis, poikilocytosis hemolysis? - microspherocyte abnormal red cell: target, schistocyte etc 34. Investigation : for definite diagnosis Inclusion body - thalassemia saline agglutination - AIHA Hb typing - thalassemia Coomb's test - AIHA Bone marrow - AA 35. 36. 37. 38. PI 2-3 month PTA รู้สึกว่ามีอาการเหนื่อย เพลียง่าย no orthopnea, no PND และสังเกตว่ามีขาบวมทั้ง 2 ข้าง ปัสสาวะอุจจาระปรกติ Case 1 CC: เหนื่อยเพลียง่ายมา 2-3 เดือน ตรวจร่างกายเบื้องต้นพบว่าผู้ป่วยซีดมาก ปัญหาผู้ป่วยจากประวัติคือ ? อายุ 79 ปี Chronic anemia 39. 40. 41. 42. Chronic anemia Dark urine Family history Hx of bl. transfusion PNH MAHA Thalassemia HS RBC production Hemolysis IVH EVH 43. PI 2-3 month PTA รู้สึกว่ามีอาการเหนื่อย เพลียง่าย no orthopnea, no PND และสังเกตว่ามีขาบวมทั้ง 2 ข้าง ปัสสาวะอุจจาระปรกติ Case 1 CC: เหนื่อยเพลียง่ายมา 2-3 เดือน ประวัติเพิ่มเติม ไม่เคยมีตาเหลือง สีปัสสาวะปรกติ รับประทานอาหารตามปรกติ ไม่มีประวัติเสียเลือดเรื้อรัง ไม่มีโรคประจำตัว อายุ 79 ปี 44. 45. Reticulocyte count: 3.91 % Investigation CBC: Hb 3.7 g%, HCT 12.7 %, WBC 18,300 /mm 3 , plt 557,000 /mm 3 N 77 %, L 12 %, M 8 %, E 3 % MCV 73.6 fl, MCH 21.6 pg, MCHC 29.5 g/dl , RDW 25.8%) (85-95) (28-33) (32-36) (12-13.6) Correct reticulocyte = 3.91 x 12.7 40 = 1.24 46. 47. 48. 49. 50. CC: เหนื่อยเพลียง่ายมา 2 สัปดาห์ PI: 2 สัปดาห์ก่อนมีอาการเหนื่อย เพลียง่ายเวลาทำงาน ร่วมกับมี อาการเวียนศีรษะเวลาลุกขึ้นเร็วๆ มีอาการใจสั่นเป็นบางครั้ง อาการ เป็นมากขึ้นเรื่อยๆ Case 2 44 ปี 51. Physical examination BP 120/80 mmHg, PR 86 /min, RR 16 /min Liver was palpable, 1 FB below RCM Spleen was palpable 1 FB below LCM 52. 53. CBC: Hb 7.7 gm%, HCT 20 %, WBC 8,300 /mm 3 . Platelet 317,000 /mm 3 N 54 %, L 29 %, M 8 %, E 8 %, B 1 %, NRC 1/100 Investigation Reticulocyte 12.7 % MCV 120 fl, MCH 33.6 pg, MCHC 36.3 g/dL, RDW 17.5 % (85-95) (32-36) (32-36) (12-13.6) Corrected reticulocyte = 12.7 x 20 40 = 6.35 54. 55. 56. 57. 58. 59. ผู้ป่วยชายอายุ 16 ปี มีอาการเหนื่อยเพลียมาก มา 1 สัปดาห์ ปัสสาวะสีดำ pale, jaundice, no hepatosplenomegaly Case 3 Anemia + jaundice Acute hemolysis Acute intravascular hemolysis Dark urine 60. 61. 62. 63. 64. ผู้ป่วยชายอายุ 16 ปี มีอาการเหนื่อยเพลียมาก มา 1 สัปดาห์ ปัสสาวะสีดำ pale, jaundice, no hepatosplenomegaly G-6-PD deficiency with acute hemolysis investigation 65. 66. ผู้ป่วยหญิงอายุ 20 ปี มีประวัติซีดเหลืองมาตั้งแต่เด็ก ตรวจพบว่ามีตับและม้ามโต Chronic hemolytic anemia Case 4 67. Investigation CBC: HCT 23 %, WBC 5600 /mm 3 , plt - adequate, N 65 %, L 35 % MCV 65 fl reticulocyte 9 % 68. 69. 70.